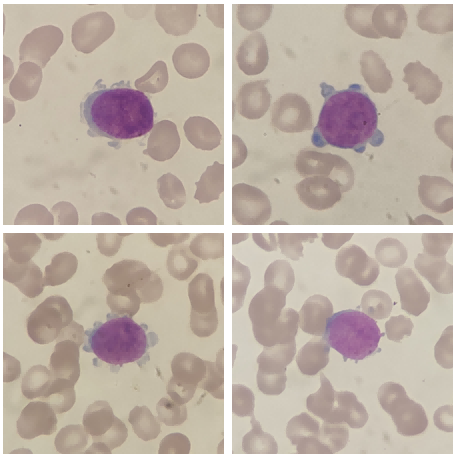

作者|杜永光
单位|河南大学淮河医院检验科
前言
急性巨核细胞白血病(acutemegakaryocyticleukemia,AMKL)是一种少见类型的白血病,1985年首次被归入到FAB急性髓系白血病(AML)分型中,命名为AML-M7,以骨髓巨核细胞克隆性增殖,常合并骨髓纤维化[1]。儿童发病率明显高于成人,尤其是伴有唐氏综合征的儿童,近一半的AMKL于3岁前发病,平均年龄为2.2岁。AMKL在成人中较少见,占所有急性髓系白血病发生率的3%-5%[2]。近来我院血液科诊断了一例成人急性巨核细胞白血病,与大家分享交流。
案例经过
患者,男性,66岁。主诉“乏力、头晕2月,发现血小板减少1天”。
现病史:2月余前无明显诱因出现乏力,伴头晕,呈一过性,休息2-3秒可缓解,无明显加重因素,伴左下肢疼痛不适,具体性质不详,呈持续性,可忍受。就诊于当地县医院,查血常规提示:血小板5×109/L,白细胞6.33×109/L,血红蛋白75g/L,红细胞1.92×109/L。为求进一步治疗,就诊我院,以“血小板减少查因”收入血液科。
既往史:“骨髓炎”术后病史30余年,自诉“冠心病”病史3年余。
查体:T37℃,P70次/分,R20次/分,Bp124/65mmHg,无异常体征。
急查血常规:

急查凝血功能:

急查生化:

贫血三项+CA125、CA199:

腹部彩超:

胸部CT:
根据初步检查结果,从血常规结果分析,三系减低,且单核细胞比例明显增高,伴有散点图异常(单核区域上方的原始细胞区域“红圈内”有大量散点,仪器误认为单核细胞,导致单核细胞比例假性增高)。工作中我们碰到这种血常规结果一定要引起高度重视,很有可能为恶性血液病。一定要按照血常规复检规则涂片镜检。

▲10*100倍血涂片
果不其然,发现原始细胞,比例高达55%,且有一部分原始细胞的胞浆有“伪足样”突起,当时我脑海中就浮现出会不会是M7?因为在天津血研所进修的时候老师就形象地比喻过M7典型的细胞形态像“小乌龟”一样,边缘有“乌龟爪”突起,难不成今天让我碰到了。
但是形态的主观性还是太强,仅仅依靠外周血形态,只能给临床提示患者为急性白血病,建议完善血液病全套检查,不过在电话中还是忍不住和临床沟通了自己的想法,让外送流式的时候加做一下巨核系的抗体。第二天骨髓涂片送到了我们细胞室,先睹为快。先看看骨髓里的细胞形态。
骨髓涂片:(由于取材干抽,增生活跃-,只能多视野拼图)

▲10*100倍骨髓

▲10*100倍骨髓MPO染色

流式细胞学:





染色体:

36种融合基因:

58种突变基因:

骨髓活检:

案例分析
急性巨核细胞白血病(AMKL)诊断标准:依据2008年WHO分型诊断标准[3]
然而实际工作中,AMKL患者的诊断存在困难,主要原因是AMKL患者常合并骨髓纤维化,容易出现干抽,导致骨髓细胞形态学检查不准确,不能获取准确的原始细胞比例,在这种情况下,假如经流式细胞学、免疫组化、超微结构的观察以及血小板过氧化物酶(PPO)检测明确为巨核细胞,可以通过评价骨髓活检中的原始细胞数量来诊断AMKL。
本病例虽然骨髓穿刺也为“干抽”,但原始细胞数量超过了急性白血病的诊断标准,且经流式细胞学检测部分原始细胞表达CD41a、CD41b、CD42a、CD61这些巨核细胞的标志,同时骨髓活检免疫组化也有CD61的表达。
遗憾的是本实验室条件有限,未能进行PAS、特别是CD41小巨核酶标等相关细胞化学染色。不能依据形态学来计数原始巨核细胞是否超过了原始细胞的50%这一标准。
不过本病例根据WHO分类原则,结合病史和MICM检查,在排除治疗相关AML、伴重现性细胞遗传学异常AML、AML伴骨髓增生异常相关改变、Down综合征相关AMKL后可以考虑诊断为急性髓系白血病非特指类型中的AMKL(即FAB分型中的M7)。
为了从临床表现和实验室检查方面进一步了解AMKL的特点,我查阅了几篇文献报道[1-2,4-6]总结如下。
临床表现方面:
文献[1-2,5-6]中报道,与其他急性白血病类型相似,常以发热、乏力、出血起病,部分患者有肝、脾、淋巴结肿大。本例患者也表现为乏力、头晕、肝脏肿大,与报道相符。
实验室检查方面
血常规:文献[1-2,5]共报道了35例患者,其中白细胞增多的有17例,正常的有9例,减少的有9例。26例患者中(有9例未报道),血小板减少的有20例,正常的有4例,增多的有2例。35例患者外周血均发现原始细胞,比例在2%-84%之间,提示我们可以通过外周血涂片初步筛查急性白血病。
骨髓涂片原始细胞比例及形态:文献[1-2,4-5]共63例中61例骨髓原始细胞比例超过20%,在20%-95%之间,只有2例骨髓原始细胞小于5%。
细胞形态:
文献[1]中描述了:原巨核细胞形态多不规则,胞质边缘有大小伪足或絮状突起,部分细胞边缘可见聚集的血小板。
文献[4]中描述:原始巨核细胞胞质较粗,核仁明显,2-4个,胞浆量中等,外形不规则、边缘不整齐、有指状突起或泡状突起;胞质可见空泡并伴伪足、部分细胞还可见到血小板生成。
文献[5]中描述了透射电镜观察结果(如图):原始巨核细胞(I期),细胞直径小于20um,外形规则,表面突起和伪足少,核轻度或中度不规则,胞质含SCCS和致密颗粒,排列无规律。
幼稚巨核细胞(II-III期):细胞体积大,表面有不规则突起或伪足,核极度不规则,呈多极、多叶形态,异染色质丰富,核仁明显,胞质量多,部分细胞含大量DMS、SCCS,以及致密颗粒和a颗粒。
流式免疫表型[2,4,6]:37例患者均表达CD41、CD42,部分患者还表达CD13、CD33,跨系抗原表达率相对较高的为CD4、CD7、CD56。不过需要注意的是由于血小板可以粘附在原始粒细胞或原始单核细胞表面,造成血小板表面标记假阳性结果,所以细胞质CD41、CD42、CD61标记,比细胞表面标记更可靠。
染色体核型:文献[1-2,4-5]中有57例患者检测了染色体,其中异常核型43例。AMKL患者染色体异常发生率高且多为复杂核型,无规律性,不过值得注意的是文献[4-5]共有9例婴幼儿患者+21染色体异常,为唐氏综合征患者,唐氏综合征患者的AMKL发生率是其他急性髓系白血病的400-500倍,在AMKL中20%-50%可继发于唐氏综合征。
总结
由于AMKL的临床表现复杂,无典型的特征性表现,有些病例可以从细胞形态上提示,但特异性不强、又存在主观因素。所以诊断AMKL还是要综合MICM分型(细胞形态、细胞化学、免疫分型、染色体、基因),有条件的可以结合电镜等检查进一步确诊。
参考文献
[1]吴宛玲,赵光杰,丁天凌等.9例成人急性巨核细胞白血病临床病例分析及文献复习[J].临床血液学杂志,2017,30(09):701-704.
[2]衡春,曹维克,李元媛等.四例急性巨核细胞白血病实验室诊断分析[J].海南医学,2016,27(18):2971-2973.
[3]SwerdlowSH,CampoE,HarrisNL,etalWHOclassificationoftumoursofhaematopoieticandlymphiodtissues[M].Lyon:IARCPress,2008:136-137.
[4]贺玲玲,骆婷婷,常艳等.28例急性巨核细胞白血病实验室检查结果分析[J].中国生物工程杂志,2019,39(09):2-10.
[5]董树旭,赵轼轩,王颖等.22例急性巨核细胞白血病的实验室检查特点分析[J].中华血液学杂志,2016,37(04):297-301.
[6]曹越,蔡元菊,杨江勇等.5例急性巨核细胞白血病患者免疫表型结果分析[J].国际检验医学杂志,2016,37(15):2074-2075+2078.